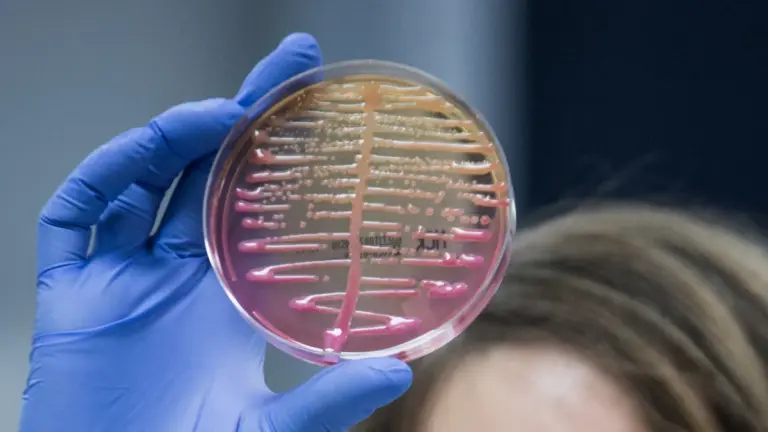
A newfound protein called 'Neo'

About Neo:
- Discovery of ‘Neo’: It was reported by researchers led by Stephen Tang and Samuel Sternberg in a 2023 preprint paper on bio Rxiv while working on Klebsiella pneumoniae.
- Mechanism: Bacteria defend themselves from viral infection (against bacteriophages) using diverse immune systems, many of which sense and target foreign nucleic acids. Defense-associated reverse transcriptase (DRT) systems are one of them.
- In the DRT-2 system, the bacteria undergo de novo gene synthesis via rolling-circle reverse transcription (RT) of a non-coding RNA (ncRNA).
- In uninfected bacterial cells, the ncRNA and RT enzyme lead to the synthesis of a repetitive single-stranded cDNA.
- The presence of phage triggers the second-strand cDNA synthesis, leading to the production of long double-stranded DNA.
- This double-strand cDNA generates messenger RNAs that encode a stop codon-less, never-ending open-reading frame (neo) whose translation (neo protein) causes potent growth arrest (cell dormancy) of bacteria. It protects the larger bacterial population from the spread of phage.
- Significance in Biotechnology and Medicine:
- It represents a potential biotechnological tool for controlling viral infections.
- Retroelements in the human genome and bacterial reverse transcriptases have a common evolutionary history as well as share functional mechanisms.
- Bacterial reverse transcriptases, believed to be the precursors of their eukaryotic counterparts, exhibit analogous mechanisms.
- Reverse transcriptase:
- The ability of cells to create DNA copies from RNA is called reverse transcription. It is performed by the enzyme called reverse transcriptase.
- Reverse transcriptase, discovered by Howard Temin and David Baltimore in 1970, has revolutionised research methods in molecular biology and is crucial in studying and managing RNA viruses like HIV.
- Reverse transcriptase is used in molecular biology to clone genes, perform PCR, and analyse genomes.
It is also used in diagnostics to detect and quantify viral loads, such as in the case of SARS-2. It also has helped track the virus’s spread, paving the way for surveillance, better public healthcare, and vaccine development.
Q1. What is a DNA?
DNA (Deoxyribonucleic Acid) is a molecule that carries genetic information, responsible for transmitting hereditary traits from parents to offspring. It is a double helix structure composed of nucleotides with four nitrogenous bases: adenine, cytosine, guanine, and thymine.
Source: The bacteria that write new genes to cope with infections
Last updated on March, 2026
→ UPSC Final Result 2025 is now out.
→ UPSC has released UPSC Toppers List 2025 with the Civil Services final result on its official website.
→ Anuj Agnihotri secured AIR 1 in the UPSC Civil Services Examination 2025.
→ UPSC Marksheet 2025 is now out.
→ UPSC Notification 2026 & UPSC IFoS Notification 2026 is now out on the official website at upsconline.nic.in.
→ UPSC Calendar 2026 has been released.
→ Check out the latest UPSC Syllabus 2026 here.
→ UPSC Prelims 2026 will be conducted on 24th May, 2026 & UPSC Mains 2026 will be conducted on 21st August 2026.
→ The UPSC Selection Process is of 3 stages-Prelims, Mains and Interview.
→ Prepare effectively with Vajiram & Ravi’s UPSC Prelims Test Series 2026 featuring full-length mock tests, detailed solutions, and performance analysis.
→ Enroll in Vajiram & Ravi’s UPSC Mains Test Series 2026 for structured answer writing practice, expert evaluation, and exam-oriented feedback.
→ Join Vajiram & Ravi’s Best UPSC Mentorship Program for personalized guidance, strategy planning, and one-to-one support from experienced mentors.
→ Shakti Dubey secures AIR 1 in UPSC CSE Exam 2024.
→ Also check Best UPSC Coaching in India